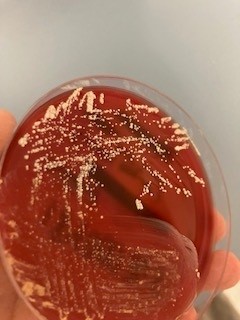
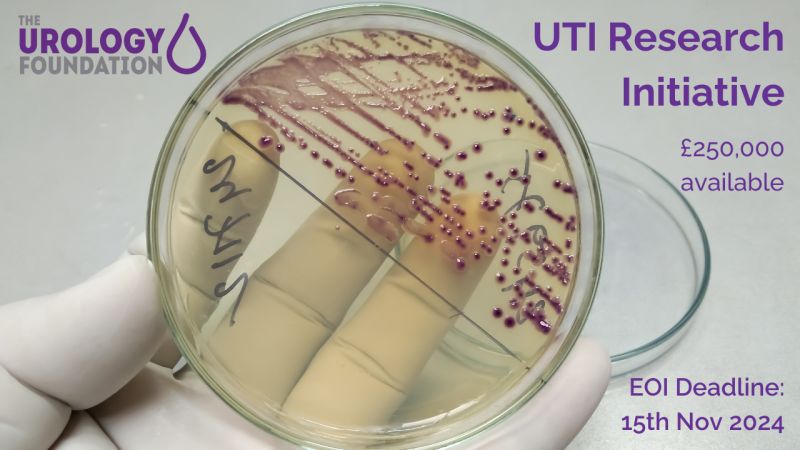

Vicki Fleming
@vicki__fleming
Consultant Clinical Scientist in Microbiology @ NUH / Microbiology science geek / A once speedy swimmer & triathlete... All views are my own.
ID: 49325236
21-06-2009 14:23:00
1,1K Tweet
499 Takipçi
494 Takip Edilen

Interested in environmental/microbiological testing and decontamination? 🦠🧫 We have an exciting opportunity for a Clinical Scientist or Biomedical Scientist to join the NUH IPC team. For more information & to apply look here 👇 nuh.nhs.uk/jobs/#!/job/UK… Association for Laboratory Medicine IBMS #AtTheHeartOfHealthcare




Have you worked with Candida auris and are interested a new role with our biofilm group? We have an 18 month Research Fellow position. We’d love to hear from you. Glasgow Biofilm Research Network ryankean29 InfectionPrevention GCU Research Centre for Health (ReaCH) myjobscotland.gov.uk/education/glas…



Exciting News from IBMS Lothian and Borders Branch branch! Today Episode 1 of a new Podcast focusing on career stories of Biomedical Scientists have launched! 🚀 🎙️👩🏼🔬🔬🧬 #BiomedicalScience #Podcast #CareersInScience #Inspiration IBMS #AtTheHeartOfHealthcare Listen here 👉 sogl.podbean.com





Insightful visit to Nottingham University Hospitals w/ @ajosephnotts, Annette, & #CwPAMS colleagues. Pleased to hear how #SSTF and #IVOS have been embedded across trust. Valuable micro lab, pharmacy tour & discussion on IPC, offering practical advice for colleagues to implement back at base.



Thanks to Antibiotic Steward Bassam Ghanem 🅱️C🆔🅿️🌟 for finding the latest Shorter Is Better study! No, not BALANCE. That ain't published yet. Rather, it's the 57th short course periop prophylaxis RCT. Yes, you heard right. 57. So...how many do you need? Kinda getting embarrassing no? bradspellberg.com/shorter-is-bet…



We are delighted to announce the publication of UTI WikiGuideline in JAMA Network Open. Thank you to the 54 experts from 12 countries for drafting. Special thanks to Snacks, PharmD, MPH and Alfredo J Mena Lora MD FIDSA for leading the effort. jamanetwork.com/searchresults?…

An early heads up that we hope to appoint a direct entry STP in microbiology in Sept 2025. Come and work with our amazing team. Keep an eye on the National School of Healthcare Science website early next year! STP Perspectives